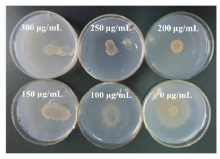

作者简介:李健(1986-),男,山东临沂人,助理研究员,博士。E-mail: lijian910@163.com
“鲁保一号”菌剂对杂草菟丝子生防效果良好,但是受制于菌种退化问题其进一步应用受到限制。本研究通过对“鲁保一号”菌的生物学性状进行分析,明确其菌种培养特性:最佳培养基为PDA培养基,最佳培养温度为25~28 ℃,最佳培养pH值为5~8。同时,利用农杆菌介导的遗传转化方法进行“鲁保一号”菌株转化,并初步构建了约含2300个阳性转化子的T-DNA插入突变体库。转化子经连续继代6次培养后潮霉素B抗性稳定,随机挑取的20个转化子均能PCR克隆出潮霉素基因,转化子是由T-DNA插入引起的,且筛选抗性能够稳定遗传。以上研究为后期筛选获得致病力稳定的遗传改良菌株,并进一步应用奠定了基础。
The application of Lubao No.1 microbial agent has been limited because of its degradation, although the strain shows high bio-herbicidal activity against Cuscuta chinensis. The results of an investigation of the biological characteristics of Lubao No.1 showed that the optimal mycelium growth medium was PDA medium. The optimal culture temperature is 25-28 ℃, and optimal initial pH of culture media was 5-8. Construction of a T-DNA insertional mutant library of Lubao No.1 using an Agrobacterium mediated transformation method, produced about 2300 positive transformants. Randomly selected transformants were all resistant to hygromycin B. A hygromycin gene fragment was amplified by PCR from all 20 tested mutants, indicating that the resistance of the transformants to hygromycin B was stable and was caused by the inserted T-DNA. This study laid the foundation for obtaining further applications of a genetically modified Colletotrichum strains with stable pathogenicity.
菟丝子(Cuscuta chinensis)是一类恶性寄生杂草[1], 其纤细的茎蔓缠绕在植物的茎秆上, 借吸根从植物体内汲取营养物质, 主要危害大豆(Glycine max)、牧草和蔬菜等作物[2, 3, 4]。“ 鲁保一号” 是山东省农业科学院刘志海等于1963年研制成功的、一种对大豆菟丝子有特殊防效的微生物菌剂[5, 6, 7]。20世纪60年代该菌剂曾在山东、江苏、安徽和宁夏等20多个省、区得到推广和应用, 推广面积达60万hm2, 防除效果在85% 以上, 有效的控制了菟丝子在以上地区的蔓延和危害[5, 6]。然而, 经过长时间的人工继代培养, “ 鲁保一号” 菌种致病力减弱, 产孢量下降, 菌剂对大豆菟丝子的致病力降低, 基本丧失了生产和应用价值[8]。
根癌农杆菌介导的遗传转化(Agrobacterium tumefaciens mediated transformation, ATMT)技术已广泛应用于双子叶植物和单子叶植物的遗传转化研究上[9, 10]。自1995年Bundock等[11]首次成功进行根癌农杆菌介导酵母菌的遗传转化以来, 到目前为止已在20多种真菌上获得成功[12, 13, 14]。ATMT法可以以不同时期的真菌作为转化受体[15], 具有受体广泛, 突变单体获得率高、转化效率高和转化子遗传稳定[16, 17, 18]等优点; 同时, 通过ATMT法把外源目的基因或核苷酸片段导入丝状真菌细胞, 为利用基因互补和基因同源重组等原理分析基因的表达调控机理乃至改造工业生产菌株指明了方向[15]。
“ 鲁保一号” 菌剂生防效果良好, 是我国迄今为止推广面积最广的一个杂草生防菌剂[19]。目前, 菟丝子在我国黑龙江、山东、天津、江苏、湖南、江西、甘肃和广州等省市广泛分布, 且在大豆、马铃薯(Solanum tuberosum)、柑橘(Citrus reticulata)和绿化植物上危害逐年严重。2007年夏, 宁夏草原大面积发生菟丝子危害, 发生总面积约为33.3万hm2, 成灾面积10万hm2, 占草原面积的4.0%[20]。目前菟丝子化学防除难度较大, 因为菌种退化问题而遗弃高效菌株无疑是对菌种资源的巨大浪费, 因此急需对“ 鲁保一号” 展开系统的研究, 解决其培养和菌种退化问题, 为工厂化生产提供技术和材料支撑。
本研究运用形态鉴定和分子生物学相结合方法对“ 鲁保一号” 菌株进行细化归类, 同时明确其多个最佳培养条件, 为下一步遗传改造和应用奠定基础。同时, 本研究利用农杆菌介导的遗传转化方法转化“ 鲁保一号” 菌株, 构建其T-DNA(transfer DNA)插入突变体库, 以期获得具有稳定致病力的遗传改良菌株, 并结合生物学特性研究, 为该菌株的重新应用奠定基础。
供试菌株和载体:农杆菌菌株AGL-1和载体pBHt2 均由山东省农业科学院植物保护研究所杂草实验室保存。“ 鲁保一号” 菌株购自中国普通微生物菌种保藏中心(China General Microbiological Culture Collection Center, CGMCC), 对该菌株连续多次回接菟丝子后获得复壮菌株为供试材料。
试验时间:本研究于2015年在山东省农业科学院植物保护研究所杂草室及温室完成。
供试培养基:本研究所用培养基马铃薯葡萄糖培养基(potato dextrose agar, PDA)、马铃薯蔗糖培养基(potato sucrose agar, PSA)、葡萄糖蛋白胨培养基(peptone dextrose agar, SDA)、真菌培养基(改良马丁培养基, fungi medium, FM)、胡萝卜琼脂培养基(carrot agar medium, CAM)和水琼脂培养基(water agar medium, WAM)等基本配方参考李健等[21]和方中达[22]的方法。基本培养基MM(minimal medium)、共培养诱导培养基(co-induction medium, co-IM)的配置方法参照黄贵修等[23]和王文娟[24]的方法配制。
将所购买“ 鲁保一号” 菌株在PDA平板上培养7~10 d, 无菌水洗下分生孢子, 通过划破法接种到菟丝子内, 保湿侵染3~4 d后, 真菌离体分离法分离菌种。连续5次复壮后, 获得致病力恢复的“ 鲁保一号” 菌株, 并以该菌株进行后续试验。
“ 鲁保一号” 菌株在PDA平板上培养7~10 d, 期间观察并记录其菌落形态。用无菌水将培养基表面的分生孢子洗下, 制成分生孢子悬浮液, 调节浓度至1× 105个孢子/mL左右。显微镜下观察“ 鲁保一号” 菌分生孢子形态。
CTAB法[25]提取“ 鲁保一号” 菌株的基因组DNA, 采用引物ITS4 (5'-TCCTCCGCTTATTGATATGC-3')和ITS5 (5'-GGAAGTAAAAGTCGTAACAAGG-3')进行PCR扩增, 将PCR产物回收后送上海生物工程有限公司进行测序。将测得序列提交到NCBI Genebank (National Center for Biotechnology Information, 美国生物信息中心), 进行BLAST分析, 并利用MEGA 6.0软件构建系统发育树。
1.3.1 培养基 PDA培养基活化“ 鲁保一号” 菌株, 7 d后, 在菌落的边缘打取直径为5 mm的菌饼, 接种到各供试培养基上, 25 ℃黑暗条件下培养10 d后测量菌落直径; 4 mL/皿无菌水洗下分生孢子, 血球计数板计数; 棉棒轻轻涂下培养基表面菌丝, 80 ℃烘箱烘烤2 h后称量干重, 以上每个试验重复3次, 每次4个重复(下同)。
1.3.2 温度和pH值 以PDA培养基为基础培养基, 接菌后将温度条件设置为19, 22, 25, 28, 31, 34和37 ℃等7个温度梯度, 接菌10 d后, 测量菌落直径、菌丝重量和产孢量。
将PDA培养基灭菌后调制成不同pH值, 设置的pH值为3, 4, 5, 6, 7, 8, 9, 10等8个梯度。25 ℃, 黑暗条件下培养10 d后, 参照1.3.1的方法统计菌落直径、菌丝重量和产孢量。
1.4.1 潮霉素B抑制浓度的筛选 为了确定潮霉素B的使用浓度, 将“ 鲁保一号” 菌分生孢子悬浮液的孢子浓度调整为1× 104个/mL, 吸取100 μ L分别接种于含潮霉素B浓度为0, 100, 150, 200, 250, 300 μ g/mL的MM培养基上, 25 ℃, 每个处理3个重复, 每隔1 d观察孢子萌发生长情况, 直至第5天, 以能够抑制孢子萌发的最低浓度为潮霉素B的最终筛选浓度。
1.4.2 分生孢子悬浮液的制备及农杆菌菌液的制备 PDA 培养基培养“ 鲁保一号” 菌株, 10 d后6 mL/皿无菌水洗下菌落表面分生孢子, 双层擦镜纸过滤, 通过血球计数板在显微镜下观察滤液中的孢子浓度, 然后用一定量的无菌水调整孢子液, 使孢子浓度达到1× 105个/mL, 备用。
挑取新鲜活化好的含双元载体pBHt2的农杆菌AGL-1单菌落, 接种于2 mL的LB液体培养基(卡那霉素50 μ g/mL)中, 220 r/min、28 ° C培养1 d, 备用。
1.4.3 农杆菌介导的遗传转化 农杆菌的遗传转化参照李伟等[26]的方法, 并略作修改。取摇好的农杆菌溶液250 μ L置于50 mL的MM培养基(卡那霉素50 μ g/mL)中, 220 r/min, 28 ℃摇床瓶培养2 d, 测量菌液的OD600值, 然后用MM液体培养基调整菌体浓度使OD600值达到0.3。将含200 μ mol/L 乙酰丁香酮(acetosyringone, AS)和1.0 mg/mL 2-吗啉乙磺酸(2-morpholinoethanesulfonic acid, MES)的co-IM(pH 5.5)培养基倒平板, 并铺一层无菌的玻璃纸于其上, 将100 μ L孢子浓度为1× 106个/mL的分生孢子和100 μ L OD600=0.3农杆菌菌液混匀后用涂布器轻涂于玻璃纸上, 25 ℃共培养36 h, 然后将玻璃纸揭下, 带菌面朝贴于PDA固体培养基(含头孢霉素、潮霉素B)上, 25 ° C培养3 d后揭下玻璃纸, 继续培养4~7 d至PDA培养基内长出转化子, 挑取转化子至新的PDA(含有头孢霉素和潮霉素B抗生素)培养基内, 编号后滤纸片法保存菌种。
1.4.4 转化子的PCR鉴定 剪取部分转化子的滤纸片在PDA培养基上进行连续继代培养, 连续培养5代后接种到含有潮霉素B的PDA培养基上, 验证其潮霉素B抗性遗传稳定性。同时挑取部分转化子菌落接种到PDA液体培养基中, 26 ℃, 180 r/min振荡培养3 d, 过滤收集菌丝体, 提取基因组DNA, PCR检测潮霉素基因(潮霉素基因引物, Hyg-F: TCGATGTAGGAGGGCGTGGA; Hyg-R: CGCGTCTGCTGCTCCATACAAG)。
“ 鲁保一号” 菌在PDA培养基培养7 d后, 菌落边缘规则, 生长初期气生菌丝为白色, 后随着分生孢子的产生转为粉红色, 分生孢子为无色单孢, 呈圆柱状, 两端钝圆(图1)。PCR克隆该菌株18S rRNA序列(图2), 并提交到NCBI Genebank, 获得Genebank号:KX263470。并通过MEGA 6.0软件构建系统发育树(图3), 同源性和进化树分析结果表明“ 鲁保一号” 菌与炭疽菌同源性较强。根据培养特性、系统发育树分析和寄主种类等结果, “ 鲁保一号” 菌株属于炭疽菌属(Colletotrichum), 为尖孢炭疽菌(C. acutatum), 具体为尖孢炭疽菌菟丝子转化型 (C. acutatum f. sp. cuscuta)。
 | 图1 “ 鲁保一号” 菌株菌落与分生孢子 A:“ 鲁保一号” 菌落Colony of Lubao No.1 strain; B:分生孢子Conidia of Lubao No.1 strain.Fig.1 Colony and conidia of Lubao No.1 strain |
2.2.1 不同培养基内的生长情况 如表1所示, “ 鲁保一号” 菌株在本研究所提供的5种真菌培养基内菌落直径不存在显著差异。但是, 综上分析菌丝重量和分生孢子产量等因素, PDA培养基为最适合“ 鲁保一号” 菌株生长和产孢的培养基, 培养10 d后其产孢量达到285.4× 109个孢子/皿左右, 远远大于其他真菌培养基。
| 表1 “ 鲁保一号” 菌在不同培养基上的生长情况 Table 1 The growth of Lubao No.1 on different culture media |
2.2.2 温度对“ 鲁保一号” 菌生长的影响 以PDA为基础培养基, 研究7个温度梯度下 “ 鲁保一号” 菌株生长状况。由表2可以看出, 综合分析菌落直径和分生孢子产量, 菌株在25和28 ℃培养条件下生长最好, 而当温度低于25 ℃时或高于28 ℃时菌落直径和产孢量均显著下降, 而相对高温(大于28 ℃)对于菌株生长的影响更大。
| 表2 温度对“ 鲁保一号” 菌株生长的影响 Table 2 Effects of the temperature on the growth of the strain Lubao No.1 |
2.2.3 pH值对“ 鲁保一号” 菌生长的影响 由表3可以看出, “ 鲁保一号” 菌其适应范围较广, 在pH 值3~10上均能生长, 其中在pH 4~9下菌落直径不存在显著差异。结合产孢量分析, “ 鲁保一号” 菌最适pH值为5~8, 在该范围内其菌落直径和产孢量均相近。而当培养基pH< 5和pH> 8时其分生孢子产量显著降低。
| 表3 pH值对“ 鲁保一号” 菌株生长的影响 Table 3 Effect of pH value on the growth of strain Lubao No.1 |
2.3.1 “ 鲁保一号” 菌株对潮霉素B的耐受性 选取 “ 鲁保一号” 菌株为材料, 在含不同潮霉素B浓度的PDA培养基上进行培养, 结果表明(图3), 在潮霉素B浓度为250 μ g/mL 的培养基上, 接种的分生孢子不能生长, 而在200 μ g/mL及较低浓度下在接种的分生孢子液边缘均长出菌丝。因此, 后续突变体库的构建过程中选取潮霉素B浓度为250 μ g/mL作为筛选浓度。
2.3.2 阳性转化子的获得与验证 共培养3~5 d后, 挑取转化子, 滤纸片法保存。经6次遗传转化共获得2267个转化子。在普通PDA平板上活化转化获得的转化子, 连续继代培养6代后, 转入含有潮霉素B的PDA平板上, 结果如图4A所示, 转化所获得突变体对潮霉素B的抗性能够稳定遗传。潮霉素基因PCR鉴定显示(图4B), 获得的转化子均能扩增出特异性条带, 回收PCR产物测序结果为潮霉素基因。
我国每年因杂草危害造成的农作物产量损失达9.7%[27]。而化学除草剂的长期使用会导致高抗性杂草的产生, 从而使得除草剂的使用陷入使用剂量逐渐增加的恶性循环, 造成严重的环境污染和食品安全问题[28, 29]。随着经济的发展, 人们环保意识的增强和对食品安全的关注, 长效无毒的生物除草剂逐渐成为当前研制和开发的热点之一[30]。
菟丝子是危害严重的寄生杂草。“ 鲁保一号” 是一种对菟丝子有特殊防效的微生物菌剂, 一度推广面积达60万hm2, 防除效果在85%以上。但是该菌株在经过较长时间的人工培养后, 菌株致病力发生退化, 基本丧失实用价值, 受制于当时的技术条件, 该菌株一度被遗弃[8]。“ 鲁保一号” 菌种发现时间较早, 加上后期退化后使用频率的减少, 缺乏关于其生物特性的系统研究, 而明确其菌株特性也是其进一步应用的先决条件。本研究显示, 该菌株能在多种培养基上生长, 且产孢量巨大, 对培养基成分要求较低; 该菌株环境适应范围广, 在多个温度条件和pH条件下均能正常生长和产生分生孢子, 以上特性说明如果能解决其菌种退化问题, “ 鲁保一号” 仍然是一个具有广阔应用价值的优良生防菌株。
优良菌株的获得是开展杂草生物防治的前提, 也是最关键因素。而对于经过实践验证的具有良好生物防效, 同时环境安全的“ 鲁保一号” 菌株来说, 因为菌种退化而被遗弃, 无疑是巨大的资源浪费。而随着科学技术的进步, 尤其是真菌遗传转化技术的日趋完善, 为通过分子生物学手段从基因层面改良生防菌, 创造优良高效菌株创造了条件[29, 30]。本研究室以探索“ 鲁保一号” 菌种退化机理为方向, 以创制致病力稳定的改良型菌株为目的, 初步运用农杆菌介导的遗传转化方法转化“ 鲁保一号” 菌株, 构建其T-DNA插入突变体库, 为后期筛选获得能够具有稳定致病力的遗传改良菌株奠定基础; 同时, 菌种退化的问题也在多种丝状真菌内存在, 是困扰生防真菌产业化生产的重要难题之一, 而与菌株退化有关基因的筛选鉴定无疑是解决这一问题的先决条件。
The authors have declared that no competing interests exist.
| [1] |
|
| [2] |
|
| [3] |
|
| [4] |
|
| [5] |
|
| [6] |
|
| [7] |
|
| [8] |
|
| [9] |
|
| [10] |
|
| [11] |
|
| [12] |
|
| [13] |
|
| [14] |
|
| [15] |
|
| [16] |
|
| [17] |
|
| [18] |
|
| [19] |
|
| [20] |
|
| [21] |
|
| [22] |
|
| [23] |
|
| [24] |
|
| [25] |
|
| [26] |
|
| [27] |
|
| [28] |
|
| [29] |
|
| [30] |
|